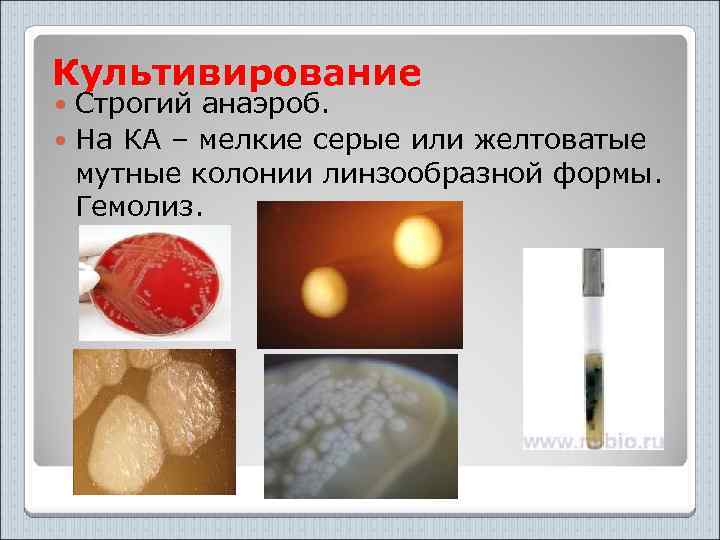
Культивирование Строгий анаэроб. На КА – мелкие серые или желтоватые мутные колонии линзообразной формы.

метод пособие по анаэробам.ppt
- Количество слайдов: 66

Возбудители анаэробных инфекций. Особенности микробиологической диагностики связи с патогенезом заболеваний. Принципы лечения, профилактика.

Составитель электронного материала для срсп и срс: кмн, ст. преп. Бегадилова Т. С.

МЕХАНИЗМ АНАЭРОБИОЗА Анаэробы не используют O 2 , т. к. у них нет цитохрома и цитохромоксидазы. У анаэробов возможно накопление H 2 O 2 т. к. отсутствует фермент перекисная дисмутаза. Анаэробы не разлагают H 2 O 2 из-за отсутствия каталазы и пероксидазы.

КЛАССИФИКАЦИЯ: Сем. Bacillaceae Род Clostridium Вид C. perfringens C. novyi ГАЗОВАЯ C. septicum ГАНГРЕНА C. histolyticum C. botulinum - БОТУЛИЗМ C. tetani – СТОЛБНЯК

Clostridium perfringens

ОСНОВНЫЕ СИМПТОМЫ ГАЗОВОЙ ГАНГРЕНЫ: “Злокачественный отек” Болезненный отек Интоксикаци я Полимикробное заболевание Зловонный запах Пузырьки газа в тканях

Морфология Cl. рerfringens A, B, C, D, E, F- 70 -80% Крупные, грамположительные, образующие капсулу палочки. Жгутиков не имеют, неподвижны, образуют при определенных условиях центральные или субтерминальные споры. Клетки разных штаммов могут отличаться друг от друга по своей толщине и длине. В одних случаях - это короткие толстые палочки, в других - длинные нити с заостренным краем клетки.


Культуральные свойства ØВ 6 - 8 ч культурах грамположительны, хорошо красятся метиленовым синим и другими основными красками. ØСтарые клетки становятся грамотрицательными. Они не воспринимают метиленовый синий и окрашивают фуксином.

Рост ч/з 3 -8 час с бурным газообразованием На агаре 4 вида колоний: S-гладкие R-шероховатые M-слизистые D-карликовые Столбик агара - “чечевица”, “аэроплан” Протеолиз желатины, мяса, молока.

Патогенное свойства 12 токсинов и ферментов: α, β, µ, s, θ, ι, κ, ή, έ, λ, γ, лецитиназа, коллагеназа, коагулаза, гиалуронидаза, ДНК-аза Высокая протеолитическая активность. Полимикробный процесс развивается в размозженных тканях при обширных ранах с карманами, затеками. Выделяющиеся токсин, ферменты вызывают коагуляционный некроз здоровой ткани. В пораженной ткани размножается новая порция микробов, процесс непрерывен. Тромбоз и разрушение сосудов. Интоксикация. Отек, газ в тканях.


C. novyi -A, B, C, D (C. odematiens) Крупные палочки На агаре ч/з 48 часов образуют «R» колонии некоторые «дают» стелющийся рост, гемолиз. Столбик агара - «линзы» или «комочки ваты» . Сахаролитическая активность (глюкозу, мальтозу, глицерин), не вырабатывают индол.

Газа нет. В пораженной мышечной ткани развивается желатинозной отек, серозная жидкость с гнилостный запахом. Лецитиназа, гемолизин, липаза, газа не образует. Образует альфа-токсин с летальным и некротическим действием – это капиллярный яд.

C. septicum A, B, C, D, E, F. палочка средней величины. Ч ерез 4 8 ч образует на агаре R- колонии. Рост « стелющийся» Столбик агара = « чечевица» , « сердце» . Образует кислородостабильный альфа -токсин с летальным, некротическим и гемолитическим действием. Г иалуронидаза , ДНК- аза , лецитиназа. В мышцах сильный отек. Развивается сильный отек тканей. Они красного цвета. На разрезе вытекает кровяная пенистая жидкость. Могут вызвать пищевые отравления.

C. Histolyticum (18% cлучаев) факультативный анаэроб На агаре сначала образуются S -колонии, затем они переходят в R-форму. На столбике агара = « чечевица» и «пушинка» Образуют альфа - токсин с летальным и некротическим действием; бетта-токсин – гистолизин. Протеиназа, гемолизин и др. Цитолиз! Выделяющиеся токсины вызывают полное расплавление тканей, вплоть до расплавление костей и отпадения конечностей. Токсикоза нет.

Рис. Обширный клостридиальный целлюлит верхней конечности посттравматического происхождения. Видны остатки самопроизвольно вскрывшихся эпидермальных пузырей. Рис. Клостридиальная инфекция культи бедра при неадекватном уровне ампутации конечности по поводу ишемической гангрены: характерная пятнисто-мраморная окраска кожи.

Рис. Рентгенограмма культи бедра при клостридиальной инфекции: обширная газовая фрагментация практически нежизнеспособных мышц. Рис. Рентгенограмма голени при открытом переломе костей, осложнившемся клостридиальной инфекцией: видны скопления газа, фрагментирующие мышцы голени.

Рис. Влажная гангрена II и III пальцев и тыла правой стопы; выражен отек стопы и области голеностопного сустава. Рис. Сухая гангрена обеих кистей, отчетливо видна демаркационная линия.

Гангрена газовая

УСТОЙЧИВОСТЬ К ФИЗИЧЕСКИМ И ХИМИЧЕСКИМ ФАКТОРАМ Токсин C. perfringens относительно быстро (несколько часов) разрушается под влиянием различных факторов внешней среды. Наибольшей устойчивостью отличаются прототоксины, которые в неактивной форме могут переносить даже кипячение (до 30 мин - 1 ч). В содержимом кишечника трупов токсины могут сохранять свою активность в течение нескольких часов, а иногда даже суток. Затем они разрушаются.

Устойчивость C. perfringens к действию различных физических и химических факторов зависит от индивидуальных свойств штамма: Вегетативные формы этих микробов быстро погибают при действии О 2, солнечного света, высокой температуры, кислот, щелочей, спиртов, дезинфицирующих средств и антибиотиков, действующих на грамположительную флору.

• Споры клостридий перфрингенс типов С, Д и Е убиваются обычно при кипячении в течение 15 30 мин. Однако отдельные штаммы типа А образуют термоустойчивые споры, переносящие кипячение или автоклавирование от 1 до 6 ч. Такие споры могут попадать из окружающей среды на сырье, используемое для изготовления различных пищевых продуктов (в том числе консервов) и способны выдержать длительную обработку. При определенных условиях жизнеспособные споры могут прорастать.

ЛАБОРАТОРНАЯ ДИАГНОСТИКА ГАЗОВОЙ ГАНГРЕНЫ Для бактериологического и бактериоскапического исследования берут экссудат, кусочки измененной ткани из раны больного, кровь из вены. Трупный материал следует брать по возможности быстрее после смерти, так как в ткани трупа могут проникать различные патогенные анаэробные микроорганизмы, всегда имеющиеся в желудочно-кишечном тракте. Все взятые материалы помещают в стерильную герметически закрывающуюся стеклянную посуду и немедленно пересылают в бактериологическую лабораторию.

Бактериоскопическое исследование Все пробы подвергают микроскопии. Готовят мазки-отпечатки и окрашивают их по Граму. Наличие большого количества крупных грамположительных палочек Ориентировочное заключение на клостридиальную инфекцию.

БАКТЕРИОЛОГИЧЕСКОЕ ИССЛЕДОВАНИЕ плотные материалы стерильно измельчают, кровь или экссудат подвергают центрифугированию в течение 30 мин. Взвесь исследуемого материала засевают на кровяной агар, агар Вильсон-Блэра и бензидиновый агар и др. Посевы инкубируют в анаэ робных условиях при 37°С, просматривают на следующий день и затем через каждые 2 дня (до 7 суток) для выделения подозрительных колоний.

Колонии, вызывающие гемолиз на кровяном агаре, проверяют на чистоту и наличие грамположительных палочек (путем микроскопии) отсевают в пробирки с жидкой казеиновогрибной средой под слоем вазелинового масла, либо на анаэробную среду Китта-Тароцци. Выделенные чистые культуры проверяют на токсичность и вирулентность, определяют чуствительность к антибиотикам биологическую пробу на лабораторных животных (мышах, морских свинках). Проводят РН токсина на животных

Биологические свойства клостридий Мочевина Гемолиз Подвижность Желатина Газ в Жидкой среде Гидролиз крахмала - - + + + + - C. Tetani C. Botulinum + - - + + + ? + ? - К- кислота, С- сгусток П- пептонизация Г- газ Изменения молока Индол C. Perfingens C. Novyi C. Septicum C. Histoliticus Вид микроба КГС КСП КС П Слабо. П

Экспресс – методы диагностики: ØИммунохимические - Лецитиназная проба: для быстрого обнаружения и серологической идентификации альфа токсина клостридий в раневом отделяемом определяют его лецитиназную активность в реакции нейтрализации с моновалентными антисыворотками против токсинов клостридий разных видов. Биохимические и молекулярно-биологические исследования исследуемый материал, полученный из очага инфекции, используют для обнаружения ДНК возбудителя с помощью ПЦР. В случае обнаружения соответствующих молекул можно поставить предварительный диагноз. ГЖХ (метод газожиткостной хроматографии) используют для обнаружения в материале от больного специфических метаболитов клостридий, включая летучие жирные кислоты с короткой цепью, спирты и нелетучие органические кислоты

Столбня к (tetanus) инфекционная болезнь, характеризующаяся тоническим напряжением скелетной мускулатуры и приступами тетанических судорог, обусловленных поражением центральной нервной системы токсином возбудителя. C. tetani (tetanos- оцепенение, судороги) - среда обитания (кишечник животных и человека, откуда попадают в почву. Там вегетируют или образуют споры.

Морфология C. tetani - это подвижная палочка с закругленными концами. Образует крупные споры, в результате этого приобретает вид барабанной палочки. Имеет жгутики, подвижны. Хорошо окрашивается всеми анилиновыми красками. По Граму красится положительно, но в старых культурах встречаются и грамотрицательные особи. Споры окрашиваются плохо. При окраске метиленовым синим или по Граму споры имеют вид колечек.


БИОЛОГИЯ, КУЛЬТУРАЛЬНЫЕ СВОЙСТВА Возбудитель столбняка - строгий анаэроб и очень чувствителен к кислороду. Микроб хорошо растет в глубине жидких питательных сред, при наличии в них глюкозы, кусочков печени или мышц (среда Китта. Тароцци). Для культивирования столбнячной палочки применяют бульон Мартена (мясо-пептонный с добавлением глюкозы, подщелоченной р-ром соды) среду Вейнберга (мясной агар). Питательные среды должны иметь нейтральную или слабокислую реакцию. Жидкие среды заливаются слоем вазелинового масла и перед посевом из них удаляют кислород путем кипячения на водяной бане в течение 1015 мин. Оптимальная температура роста 35 -37 °С.

§На плотных питательных средах - кровяном и печеночном агаре - столбнячная палочка растет только при полном удалении кислорода. На чашках с агаром при температуре 35 -37 °С через 2 -4 суток вырастают отдельные прозрачные или слегка сероватые колонии величиной 2 -5 мм с неровной зернистой поверхностью, края шероховатые, ветвящиеся. §На КА - гемолиз. §В столбике желатина через 5 -6 дней растет в виде елочки, желатина при этом не разжижая.

Резистентность возбудителя столбняка Вегетативная форма бактерий столбняка мало устойчива к воздействию температуры и химических агентов, тогда как их споры обладают значительной устойчивостью. Во влажной среде споры выдерживают нагревание до 80 °С в течение 4 - 6 ч и более, при кипячении они погибают через 40 -50 мин. В сухом состоянии споры переносят еще более высокие температуры, нагревание при 115 °С разрушает их только через 20 мин, споры совершенно не чувствительны к низким температурам. Они годами переносят температуру 40 -60 °С,

• 1%-ный раствор сулемы или 5%-ный раствор карболовой кислоты убивает споры только через 1012 ч. • Под действием рассеянного света споры погибают только через длительное время. Будучи защищены от света в почве и на различных предметах внешней среды споры могут сохраняться в течение десятков лет. • В условиях анаэробиоза при температуре 37 °С, достаточной влажности и в присутствии аэробных бактерий (стафилококки, сенная палочка и др. ) споры прорастают в развивающиеся вегетативные формы.

В биохимическом отношении возбудитель столбняка малоактивен, обладает слабовыраженными сахаролитическими и протеолитическими свойствами. Антигенная структура - по антигенной структуре возбудитель столбняка неоднороден. Выделяют групповой соматический О-антиген и типоспецифический жгутиковый Н-антиген, по которому различают 10 серологических типов. Все они вырабатывают один и тот же специфический токсин.

Факторы патогенности Основной фактор патогенности- экзотоксин Экзотоксин является одним из сильнейших бактериальных ядов, уступая по силе лишь ботулиническому токсину. Токсин не содержит углеводов, относится к протеинам. Он малостоек, быстро разрушается под влиянием нагревания, солнечного света, щелочной среды. Ферменты и энзимы ЖКТ не разрушают токсин, но он не всасывается через слизистую оболочку кишечника, в связи с чем безопасен при попадании через рот. Под действием формалина и содержание в термостате при 37 -38 °С в течение суток токсин утрачивает ядовитые, но сохраняет антигенные свойства. Полученный таким образом столбнячный анатоксин используют для активной иммунизации против столбняка.

Компоненты экзотоксина: - Тетаноспазмин, поражает нервную ткань (функциональный блокатор)-подавляет выход тормозных нейромедиаторов в синапсах, что приводит к гипервозбудимости нервных окончаний и развитию спазма мышц. - Тетанолизин, лизирует эрироциты, обладает кардиотоксическим свойством (мембранотоксин).

Эпидемиология Источником возбудителя инфекции являются животные (лошади, коровы, овцы, козы, свиньи, ослы, обезьяны, кролики, крысы, мыши) и человек, в кишечнике которых часто обитает возбудитель в вегетативной форме, но выделяемый им токсин кишечной стенкой не всасывается. Возбудитель широко рассеивается с фекалиями в окружающей среде, прежде всего в почве. Заражение происходит лишь при проникновении возбудителя в организм через дефект кожи или слизистых оболочек — раны, ожоги, отморожения. мелкие бытовые травмы и др. Больной столбняком не заразен.

Локализация палочки столбняка в организме больного Только место входных ворот Входные ворота при столбняке новорожденных пупочный канатик Входные ворота при столбняке рожениц- слизистая оболочка матки.

Патогенез. Входными воротами при С. могут быть различные повреждения наружных покровов (раны, ожоги, отморожения, электротравмы, аборты, роды, операции, язвы, пролежни и др. ). При попадании в рану спор возбудителя из них образуются его вегетативные формы, продуцирующие токсин, который гематогенным путем и по волокнам периферических нервов проникает в спинной и продолговатый мозг. Токсин снимает тормозное действие вставочных нейронов на мотонейроны. В результате этого усиливается эфферентная импульсация, возникает тоническое напряжение мышц. Появление судорожных приступов связано с усилением афферентных импульсов при действии звуковых, световых и других раздражителей. При столбняке также поражаются жизненно важные центры продолговатого мозга. Причинами смерти являются асфиксия во время судорожного приступа, паралич дыхательного и сосудодвигательного центра, пневмония, сепсис.

Поза больного в состоянии опистотонуса. Опистото нус (opisthotonus; Описто- + греч, tonos напряжение) тоническое сокращение мышц спины и шеи с запрокидыванием головы, вытягиванием конечностей, иногда спастическим прижатием рук к груди; наблюдается, например, при поражении верхних отделов ствола мозга.

ЛАБОРАТОРНАЯ ДИАГНОСТИКА СТОЛБНЯКА исследуется материал, взятый из раны: гной, кусочки тканей, инородные тела, обрывки одежды, тампоны, закладываемые в рану при перевязке, перевязочный материал, содержащий выделения из раны, в случаях столбняка после родов или аборта берут на исследование выделения из влагалища и матки.

При подозрении на столбняк у новорожденного исследованию подвергают выделения из пуповины, при исследовании трупа также берут материал из раны, если она имеется, из различных воспалительных очагов и старых рубцов. В некоторых случаях столбняка происходит генерализация инфекции, возбудитель может быть обнаружен во внутренних органах. Поэтому берут на исследование от трупа кровь, кусочки печени и селезенки. Исследование материала производится с целью обнаружения в нем столбнячного токсина и возбудителя столбняка.

ОБНАРУЖЕНИЕ СТОЛБНЯЧНОГО ТОКСИНА: Бактериологический метод: исследуемый материал растирают в стерильной ступке, добавляют двойной объем физиологического раствора. Часть материала засевают в 2 флакона с жидкой питательной средой (бульон Мартена, бульон Вейнберга) под слоем вазелинового масла. Перед посевом из среды удаляют кислород путем кипячения 15 мин, а затем охлаждают до 40 -50 °С и в нее добавляют 0, 5 % глюкозы. После культивирования при температуре 35 °С на 2 -е, 4 -е, 6 -е и 10 -е сутки микроскопируют мазки из посевов. Исследуют культуральную жидкость на наличие столбнячного токсина. Для этого ставят реакцию нейтрализации с противостолбнячной сывороткой. При обнаружении в посеве столбнячного токсина и наличии грамположительных палочек с крупными спорами дают положительный ответ. Бактериологический метод не дает своевременного результата

Биопроба: для постановки реакции нейтрализации на животных экстракт исследуемого материала вводят внутримышечно 2 мышам по 0, 5 мл экстракта, а еще двум мышам те же дозы с противостолбнячной сывороткой. В зависимости от количества токсина симптомы столбняка у животных развиваются на первые или вторые сутки. У животных, получивших токсин с противостолбнячной сывороткой симптомы не появляются, что свидетельствует о наличии в исследуемом материале столбнячного токсина.

Иммунитет - напряженный, длительный (связан с вакцинацией) Профилактика: АКДС, АДС, секс-анатоксиндети с 3 - х месяцев Для пассивного иммунитета – противостолбнячный человеческий иммуноглобулин (ПСЧИ)-вводят дробно по Безредке. Люди, получившие травмы, ожоги, отморожения и т. д. , - контингент для экстренной вакцинации против столбняка.


C. botulinum A, B, C, E, F, G Ботулизм –тяжелая пищевая токсикоинфекция. Botulus – колбаса

Подвижная Морфология палочка. Спора располагается терминально и субтерминально.
Культивирование Строгий анаэроб. На КА – мелкие серые или желтоватые мутные колонии линзообразной формы. Гемолиз.

Антигены Н-жгутиковые группоспецифические АГ О-соматические типоспецифические. Эпидемиология Естественный резервуар – почва и различные животные. Наибольшая опасность – мясные, рыбные и овощные консервы домашнего приготовления.

C. botulinum вырабатывает летальный белковый нейротоксин, состоящий из компонентов нейротоксин, гемагглютинин, нетоксичный белок. Выработка токсина связана с лизогенизацией клетки, т. е. с наличием у микроба умеренного фага, который контролирует выработку гемотоксина. Этот токсин самый сильный из всех биологических ядов. Патогенность

Патогенез Токсин с пищей – ЖКТ – кишечник – кровь – передние рога спинного мозга – параличи мышц. Нервнопаралитические явления – нарушения глотания, дисфагия, офтальмоплегический синдром. Параличи глазных, глоточных и гортанных мышц. Различают ботулизм, раневой ботулизм, ботулизм новорожденных

Патогенез и патоморфология Нарушение дыхания (частое, поверхностное) Парез мышц диафрагмы, брюшного пресса, межрёберных мышц, гипоксия Мышечная слабость, парезы, параличи Нарушение передачи нервных импульсов, гипоксия, метаболические нарушения Тахикардия, повышение АД Гипоксия, повышение активности симпатико-адреналовой системы (увеличение содержания катехоламинов) Сухость во рту, нарушение глотания, гнусавость голоса, ограничение движения языка Поражение ядер V, IX, XII черепных нервов Нарушение конвергенции, птоз, диплопия Поражение ядер III, IV черепных нервов

Широкие зрачки, нарушение зрения, аккомодации Поражение n. m. ciliares Амимия Поражение лицевого нерва Вздутие живота, запор Угнетение функции блуждающего нерва, увеличение содержания катехоламинов Рвота, одно- или двукратное послабление стула в начальный период Местное действие ботулотоксина, действие другой флоры, содержащейся в продукте Задержка мочеиспускания Поражение вегетативной нервной системы, преобладание симпатической активности, снижение тонуса мочевого пузыря Бледность кожи Сужение капилляров кожи


Клиническая картина Инкубационный период протекает от нескольких часов до 2— 5 дней, составляя в среднем 18— 24 часов. При более коротком инкубационном периоде наблюдается, хотя и не всегда, более тяжёлое течение болезни. Клиническая картина ботулизма складывается из трёх основных синдромов: паралитического; гастроинтестинального; общетоксического.


Лабораторная диагностика Материал: остатки пищевых продуктов, кровь, испражнения, моча, рвотные массы, секционный материал. 1. Бактериологический метод 2. Биологический – реакция нейтрализации на мышах. Белым мышам внутрибрюшинно вводят жидкость, полученную после центрифугирования сыворотки крови больного в смеси с противоботулинической сывороткой типов А, В, Е.

Исследование проходит 4 дня. За это время мыши, не защищённые тем типом антитоксина, которым вызвано заболевание у пациента, погибают. Остаются живыми мыши, которым вводили сыворотку, соответствующую типу токсина, циркулирующего в крови больного. Серологических исследований не проводят, так как заболевание не сопровождается выработкой выраженных титров антител, что связано с незначительной дозой токсина, вызвавшей поражение.


Методы диагностики Общеклинические методы диагностики, такие, как анализы мочи, кала, каких-либо особенностей, характерных для ботулизма, не имеют. Учитывая выраженные метаболические нарушения, показан контроль кислотно-основного состояния в динамике. При дифференциальной диагностике с нейроинфекциями важное значение при нечёткости клинической картины и не убедительных результатах РН токсина приобретают исследования ликвора (при ботулизме не изменена).

Материалом для бактериологического исследования служат фекалии и рвотные массы больного, промывные воды желудка и кишечника, содержимое ран (при раневом ботулизме), подозреваемая пища. Так как сразу поставить диагноз «ботулизм» у взрослого больного сложно, то проводят обнаружение токсина в исследуемом материале.

Лечение Антитоксическая ботулиническая сыворотка. Профилактика Ботулинический полианатоксин Соблюдение санитарно-гигиенических правил при производстве пищевых продуктов.
метод пособие по анаэробам.ppt